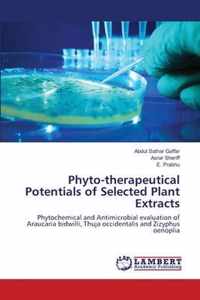
Phyto-therapeutical Potentials of Selected Plant Extracts

potentials of spaces online kopen
Ben je op zoek naar potentials of spaces? Bekijk onze boeken selectie en zie direct bij welke webshop je potentials of spaces online kan kopen. Ga je voor een ebook of paperback van potentials of spaces. Zoek ook naar accesoires voor potentials of spaces. Zo ben je er helemaal klaar voor. Ontdek ook andere producten en koop vandaag nog je potentials of spaces met korting of in de aanbieding. Alles voor veel leesplezier!
Morrey Spaces
In this set of lecture notes, the author includes some of the latest research on the theory of Morrey Spaces associated with Harmonic;
Vergelijkbare producten zoals Morrey Spaces
Potentials of Spaces
The Potentials of Spaces interrogates the relationship between scenography and performance in contemporary dramatic activities. The book;
Vergelijkbare producten zoals Potentials of Spaces
Harmonic Functions and Potentials on Finite or Infinite Networks
the (Newton) potential theory on the Euclidean spaces is well-established. The latter theory has been variously generalized, one example being;
Vergelijkbare producten zoals Harmonic Functions and Potentials on Finite or Infinite Networks
London Mathematical Society Lecture Note Series
invariant gradient of Green potentials. Applications of some of the results to Hp spaces, and weighted Bergman and Dirichlet spaces of invariant;
Vergelijkbare producten zoals London Mathematical Society Lecture Note Series
Strange Places
Strange Places: The Political Potentials and Perils of Everyday Spaces offers a conceptual framework for thinking politically about place;
Vergelijkbare producten zoals Strange Places
Strange Places
Strange Places: The Political Potentials and Perils of Everyday Spaces offers a conceptual framework for thinking politically about place;
Vergelijkbare producten zoals Strange Places
Modern Approaches to the Visualization of Landscapes
visualize non-visual stimuli, but also spatial-temporal changes of physical space. Another focus is on how virtual spaces have already become part;
Vergelijkbare producten zoals Modern Approaches to the Visualization of Landscapes
Covariant Schroedinger Semigroups on Riemannian Manifolds
operators on Euclidean spaces so far. In particular, the book studies operators that act on sections of vector bundles. In addition, these operators;
Vergelijkbare producten zoals Covariant Schroedinger Semigroups on Riemannian Manifolds
Aerial Play
understanding of its potentials. How should we situate drone practices in recreational spaces? What ways of seeing, moving, and being do hobby drones;
Vergelijkbare producten zoals Aerial Play
Aerial Play
understanding of its potentials. How should we situate drone practices in recreational spaces? What ways of seeing, moving, and being do hobby drones;
Vergelijkbare producten zoals Aerial Play
The Gas Exchangers
only two fluid respiratory media and essentially two habitable spaces - water and air. They must adapt to either and in rarer cases to both.;
Vergelijkbare producten zoals The Gas Exchangers
Illustrated Manual of Clinical Evoked Potentials
Evoked potentials (EPs) have been used for several decades to assess neurologic function intraoperat;...
Vergelijkbare producten zoals Illustrated Manual of Clinical Evoked Potentials
Static Fields and Potentials
Static Fields and Potentials describes two of the fundamental interactions in nature: gravity and el;...
Vergelijkbare producten zoals Static Fields and Potentials
Evoked Potentials (EPs)
Evoked Potentials (EPs) is een boek van Nova Science Publishers;...
Vergelijkbare producten zoals Evoked Potentials (EPs)
To the Hands of the Poor
Confronts the paradox of mass poverty coexisting with vast resource potentials in rural India, s;...
Vergelijkbare producten zoals To the Hands of the Poor
Applied Analysis
spaces, complex function theory, real analysis, and abstract analysis. This book also uses fundamental ideas of applied mathematics to discuss;
Vergelijkbare producten zoals Applied Analysis
The electric strength of air under continuous potentials and as influenced by temperature
The electric strength of air under continuous potentials and as influenced by temperature This book,;...
Vergelijkbare producten zoals The electric strength of air under continuous potentials and as influenced by temperature
Clinical Evoked Potentials
This book covers all aspects of evoked potentials (EPs) utilized clinically in evaluating the functi;...
Vergelijkbare producten zoals Clinical Evoked Potentials
Differenziertes Hochschulmarketing fur High Potentials
Differenziertes Hochschulmarketing Fur High Potentials is een boek van Ingo Schamberger;...
Vergelijkbare producten zoals Differenziertes Hochschulmarketing fur High Potentials
Evoked Potential Manual
J.P.C. de Weerd Evoked potentials are the electrical voltage fluctuations which can be recorded from;...
Vergelijkbare producten zoals Evoked Potential Manual
Introduction To Quantum Mechanics
After a consideration of basic quantum mechanics, this introduction aims at a side by side treatment;...
Vergelijkbare producten zoals Introduction To Quantum Mechanics
Introduction To Quantum Mechanics
After a consideration of basic quantum mechanics, this introduction aims at a side by side treatment;...
Vergelijkbare producten zoals Introduction To Quantum Mechanics
Renewable Energy Resource Potentials and Constraints in Nigeria
Renewable Energy Resource Potentials and Constraints in Nigeria is een boek van Luqman Adedokun;...
Vergelijkbare producten zoals Renewable Energy Resource Potentials and Constraints in Nigeria
Learning Cities
This book is an interdisciplinary text exploring the learning and educative potentials of cities and their spaces, including urban and;
Vergelijkbare producten zoals Learning Cities
Opportunistic Adaptation
multiple dwellings, infrastructure as well as public spaces. An extensive catalogue of adaptation measures for different scale-levels ensures;
Vergelijkbare producten zoals Opportunistic Adaptation
Potentials of Some Nigerian Plant Resources
Vergelijkbare producten zoals Potentials of Some Nigerian Plant Resources
Phyto-therapeutical Potentials of Selected Plant Extracts
Vergelijkbare producten zoals Phyto-therapeutical Potentials of Selected Plant Extracts
Einde inhoud
Geen pagina's meer om te laden'